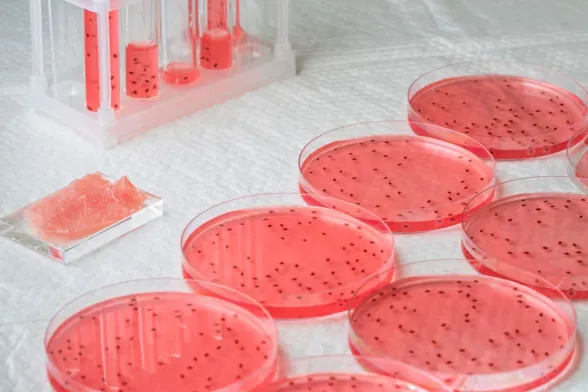

Il mondo, come oggi lo conosciamo, è destinato sicuramente a cambiare. Le grandi questioni ambientali, infatti, potranno essere affrontate soltanto con drastici cambiamenti che dovranno riguardare, chi più e chi meno, tutta la popolazione. Tra i temi sul tavolo, ma in questo caso non sarebbero dire sulla tavola, anche quello relativo agli allevamenti intensivi di animali, eccessivamente inquinanti e dunque non più compatibili con un’economia che dovrebbe essere amica dell’ambiente. E gli attori che sono scesi in campo per trovare alternative sono tanti, anche perché gli interessi economici sono grandi.

Addio agli allevamenti intensivi
Gli allevamenti intensivi sono responsabili del 14,5 per cento di tutte le emissioni di gas a effetto serra di origine antropica. Si stima inoltre che per gli animali da macello venga usato il 20 per cento delle terre emerse (come pascolo), a cui va aggiunto un ulteriore 40 per cento di terre indispensabili per la produzione di mangimi. Insomma, non si può andare avanti così. Le alternative alla carne comunque esistono, e sono sostanzialmente tre:
- carne vegetale;
- carne stampata;
- carne coltivata.
Carne “sintetica”
Partiamo col dire che il termine, “carne sintetica” è – se non errato – quantomeno improprio. La carne, infatti, non nasce come per magia in laboratorio, ma viene semmai “coltivata”, a partire da cellule prelevate da mucche. Fatto questo vanno nutrice e fatte moltiplicare in vitro. Alla fine del procedimento si ottengono dei “blocchi di carne” grazie ai quali è possibile preparare dei tagli specifici. Al momento questa tecnica è stata sperimentata con bovini, maiali, tacchini, polli, anatre e pesci, ma si può tentare con qualunque specie. Le cellule estratte dall’animale vivo vengono trasferite in un bireattore che riproduce le condizioni ottimali di temperatura, aerazione e di nutrienti, replicando quelle presenti nel corpo degli animali. Le cellule si moltiplicano e si differenziano, formando le unità base delle fibre muscolari. La tecnica, che comporta l’uso di animali vivi, permetterebbe di ottenere da ogni singola mucca 175 milioni di hamburger, contro i 500 mila pezzi ottenibili da una normale macellazione. La carne coltivata così ottenuta ha le medesime caratteristiche nutrizionali della normale carne, ma il suo costo di produzione è decisamente proibitivo. L’obiettivo è quello di riuscire - ma siamo ben lontani - a produrre carne coltivata con un prezzo di mercato che non superi i 20 euro al chilogrammo.
La carne “vegetale”

Non è carne, e proprio per questa viene sostenuta da milioni di persone che già oggi abbracciano una dieta vegetariana o vegana. I primi prodotti sono sbarcati sul mercato poco meno di 4 anni fa, e sono tutti caratterizzati dall’esser composti prevalentemente da farina di ceci, piselli, fagioli verdi, soia o altri legumi. Tra gli ingredienti secondari, poi, ci sono olio di canola, di cocco, di cacao e barbabietola rossa, usata per dare al prodotto il caratteristico colore della carne.
La via di mezzo, ecco la carne “stampata”

Tra i prodotti interamente “coltivati” e quelli “vegetali” c’è poi una versione intermedia, la cosiddetta carne “stampata” grazie a dispositivi 3D che ricreano di fatto bistecche, salsicce o banalmente polpette con tanto di stratti di grasso visivamente “quasi naturali”: le stampanti consentono infatti di riprodurre la struttura di un muscolo in maniera estremamente dettagliata. Tra gli ingredienti troviamo la carne “coltivata” e gli ingredienti vegetali che hanno il compito di conferire consistenza e colore al prodotto finito.
I possibili rischi per la salute
Escludendo la carne “vegetale”, che carne non è, perché integralmente costituita da normali colture vegetali, le altre tipologie di carne “Frankenstein”, così viene definita da ambientalisti e animalisti, potrebbero presentare rischi, ancora oggi sconosciuti. Al momento, le ricerche condotte nei paesi dove la produzione di carne coltivata è considerata legale, non hanno evidenziato rischi per il consumatore.
I dubbi comunque restano
Rachel Mazac, ricercatrice dell’Università di Helsink, non si esprime sui possibili rischi per la salute: “Non posso dirlo con certezza – spiega - ma questi cibi devono passare per la Novel Food Regulation europea, data la relativa novità della tecnologia. E’ necessario confermare la loro sicurezza al pari delle altre opzioni attualmente disponibili per i consumatori europei. In questa fase penso che non siano né più né meno sicuri rispetto alla carne ottenuta in modo convenzionale”.
Per il momento i produttori parlano soltanto dei pro
Al momento, dunque, non vi sono apparenti dubbi sulla sicurezza di questo alimento. E i produttori non ne evidenzieranno di certo le possibili criticità che, nel caso, verranno a galla pian piano. Di sicuro il lancio di questi prodotti promuoverà (indirettamente) la salvaguardia degli animali: si potrà evitare l’uccisione di milioni di animali. L’attenzione delle istituzioni è già massima. In un documento dell’Agenzia europea per l’ambiente (LEGGI QUI) si evidenzia che la nuova tecnologia produttiva potrebbe anche “offrire modi per controllare la composizione della carne e così da renderla più salutare”. Si potrebbero infatti stabilire dei livelli “sicuri” per i grassi insalubri, o meglio sostituirli con i più salutari Omega-3. Si potrebbero eventualmente includere anche degli ingredienti non presenti nella normale carne, come le vitamine.
La carne coltivata, inoltre, non necessita di antibiotici. L’alimento viene fatto crescere in ambienti sterili, a partire da animali sani che verrebbero usati per il prelievo di cellule… questa immagini in effetti è decisamente inquietante! Le rigide procedure di controllo, necessarie durante tutto il processo di crescita, potrebbe inoltre favorire una diminuzione delle malattie zootecniche”, comuni nei normali allevamenti intensivi.
L’impatto positivo sull’ambiente
Produrre carne coltivata avrebbe poi un impatto positivo anche sull’ambiente:
- Consumi elettrici giù del 45 per cento
- Utilizzo del suolo -99 per cento
- Consumo idrico ridotto dell’82-96 per cento
- Emissioni di gas serra pesantemente ridotte
L’allevamento di animali da macello è da solo responsabile del 14,5 per cento del totale di tutte le emissioni di gas a effetto serra di origine antropica.
I pro sono (sembrano) pertanto moltissimi, ma resta da convincere il consumatore. Le Nazioni Unite da anni tentano di mostrare la nuova via da percorrere, ma insetti e carne creata in laboratorio non sembrano incuriosire tanti che non vogliono rinunciare alla classica bistecca. Anche Animal Equality, organizzazione internazionale non-profit per la difesa dei diritti degli animali, si è espressa in sostegno di questa nuova industria, che in qualche modo dovra in ogni caso servirsi di “animali cavia” che vivranno una vita d’inferno. “Gli animali che vengono allevati – spiega Animal Equality – vivono in condizioni terribili in ambienti sovraffollati, a contatto con le loro deiezioni e gli allevamenti spesso sono ambienti insalubri e vere e proprie polveriere dove rischiano di esplodere nuovi virus. La carne coltivata, invece, verrebbe prodotta in ambienti altamente controllati, dove i rischi di contagio e malattie infettive sono molto bassi”.
La carne coltivata rappresenterebbe quindi una soluzione sostenibile e anche più etica. La carne coltivata è già presente nei banchi frigo di molti negozi a Singapore e persino negli Stati Uniti. In Europa ci si muove come spesso accade in ordine sparso. Il Italia, il Consiglio dei Ministri ha recentemente approvato un disegno di legge che vieterà la produzione e anche la vendita di cibo prodotto in laboratorio a partire da cellule animali. Per alcune associazioni tale decisione è un clamoroso passo indietro per animali, per l’ambiente e anche per lo sviluppo scientifico.

